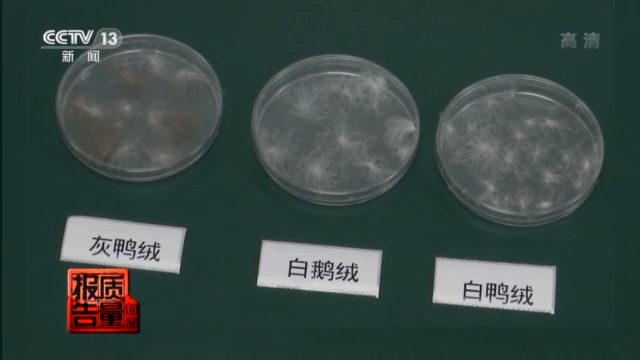

文 | 央视新闻客户端
要对某类产品进行质量监督抽查,检测机构一般都会选择这类产品正热销的时候,而从抽样开始到出结果,都需要一定的程序过程,所以出最终抽查结果的时间就会错后,但向消费者提供可靠的质量信息,任何时候都是需要的。
最近,江苏省市场监管局公布了冬季用品的监督抽查结果。检测人员说其中有一款儿童羽绒服,是她从业以来见过的质量最差的羽绒服。
以次充好,羽绒服、围巾不合格率严重超标
江苏省市场监督管理局日前对羽绒服、羽绒被、围巾、棉服、冲锋衣和羊绒衫等冬令用品进行监督抽查,结果发现:羽绒产品的填充物质量、服装面料的纤维含量等方面,以次充好,是不合格产品存在的主要质量问题。
江苏省市场监管局监督处副处长 郭亮:这次监督抽查我们江苏省市场监管局主要在羽绒服、羽绒被等六大类冬令服装抽查了350批次,一共发现43批次不合格,不合格发现率为12.3%。



记者注意到,羽绒服和羽绒被是这次监督抽查的重点,共抽查185批次,占总数350批次的一半以上。其中,羽绒被抽查45批次,由南京市产品质量监督检验院和南通市纤维检验所共同检测;成人羽绒服抽查80批次,儿童羽绒服抽查60批次,由常州市纤维检验所、苏州市纤维检验院和大加利(太仓)质量技术检测中心等机构联合检测。

大加利(太仓)质量技术检测中心高级工程师 姜文良:这件成人羽绒服标注填充的羽绒为134克,我们实际测试下来发现只有90克,少了近三分之一,根据羽绒服国家标准规定,只允许5%的偏差,这种缺斤短两,属于严重的不合格。
羽绒服里填充物压根不是羽绒
记者在检测现场看到,一些羽绒服不仅充绒量存在严重偏差,而且有的填充物根本就不是真正的羽绒。
大加利(太仓)质量技术检测中心高级工程师 姜文良:国家标准规定羽绒服的填充物主要是像这样一朵一朵的带有绒核结构的朵绒形成的,这种朵绒堆在一起它可以聚集较多的空气,我们知道空气的热度大,由朵绒形成的羽绒服具有良好的保暖性能。我们检测发现这件羽绒服它的填充物主要是一根一根的羽丝,不是带有绒核结构的朵绒。我们知道这个羽丝主要是由羽毛粉碎后形成的,它的保暖性很差。

这种带有“绒核”结构的朵绒,才是真正的羽绒。由朵绒填充的羽绒服,才具备良好的保暖效果。国家标准规定,羽绒服的主要填充物不仅要求是朵绒,而且对朵绒的占比,也就是含绒量做出明确要求。
大加利(太仓)质量技术检测中心高级工程师 姜文良:这件儿童羽绒服标注的含绒量为90%,我们测试下来发现含绒量有3.3%,虚标了近30倍。根据国家羽绒服标准的规定,含绒量偏差只允许3%,这个属于严重的不合格,这件衣服的话严格上来说已经不能算羽绒服了,因为羽绒服标准规定含绒量至少要50%。
检验人员:这是我从业以来见过最差的羽绒服
记者观察发现,这次抽查中,不合格儿童羽绒服的质量更为堪忧。像这样含绒量达不到国家标准规定的50%以上,不能算是羽绒服的样品,并不罕见。
这款从电商平台购买的,标称为“优卡缇”牌加厚儿童羽绒服,衣服明示含绒量为80%白鸭绒,店铺宣称“我们的内心羽众不同”,主打“柔软、保暖、透气、蓬松”等特点,然而,检测人员却告诉记者,这是她从业以来见过质量最差的羽绒服。

苏州市纤维检验院检验部助理工程师 沈花:它的标签,它的含绒量是80%的白鸭,但实际上我们抽到了它的含绒量只有1.7%,那它里面其实全是这种羽毛上掉下来的丝,正常我们的羽绒呢应该是这样子的绒朵,很大朵的,然后这样才能隔绝空气保暖,这几乎是我从业以来检测过的最差的羽绒服了。
擦亮双眼,这些牌子不合格
经过检测,8批次成人羽绒服不合格,包括标称为雪中飞牌、标称为戎美牌、标称为爱狼仕牌、标称为冰洁牌等样品。

11批次儿童羽绒服不合格,包括标称为优卡缇牌、标称为谷米熊牌、标称为棉小班牌、标称为小海员牌等。

在进一步的采访中记者发现,这次监督抽查从电商平台买样的羽绒被,标称的填充物和实际填充物完全不同。

南通市纤维检验所高级工程师 钱薇薇:这床被子它号称是100%的鹅绒被,其实通过我们检测下来,里面一点鹅绒都没有。
经过检测,这款从直播平台购买,标称为“上海怡庭纺织科技有限公司”生产的羽绒被,有四项指标不合格,包括纤维含量、绒子含量、鸭毛绒含量和蓬松度等,也就是说,它的面料和填充物,都不合格。
南通市纤维检验所高级工程师 钱薇薇:根据它的那个吊牌上,它的面料显示是100%的全棉,但是我们检测下来它的棉含量只有57%,其他都是聚酯纤维。它标称绒子含量是95%,而我们检测下来绒子含量只有7.8%,连它的十分之一都不到,严格意义上来说这条被子连羽绒被都算不上,因为国家标准里面要求,绒子含量要大于等于50%的,才能称为羽绒被。
记者看到,这款含绒量只有7.8%,都不能称为羽绒被的样品,它的包装上赫然印有“私人定制”“高端被芯制造专家”等字样,产品标签明示为“至尊白鹅绒被”,面料是高支高密全棉,填充物95%白鹅绒,甚至还提供了羽绒填充物的看样。
南通市纤维检验所高级工程师 钱薇薇:这条被子,它给消费者看的这个看样,看上去还是蛮不错的绒子,但其实这条被子里面的填充物,大多数都是这种粉碎性的毛绒。
记者:不成朵。
南通市纤维检验所高级工程师 钱薇薇:不成朵,我们的检测人员在检测过程中出现了皮肤瘙痒的情况,像这种填充物不仅保暖性能会比较差,消费者盖在身上有可能会引发皮肤瘙痒、鼻炎或者刺激呼吸道。
然而,记者翻阅检测报告时注意到,这款让检测人员皮肤瘙痒的被子,产品名称却是“典雅型抗菌白鹅绒被”。
南通市纤维检验所高级工程师 钱薇薇:根据我们平时监督抽查和委托检验来看,大部分这种羽绒被的不合格情况出现在电商平台,电商平台通常通过价格战来吸引消费者。比如说这条被子它的零售价是4580,它卖给消费者是980,但是这条被子按照它的这个实际情况,它的成本价可能只有100块钱左右,但是它还是卖了980块钱,利润还是很大。按照这条被子标称的这个质量品质来做的话,这条被子的成本要在1500块钱以上。
三个核心指标决定羽绒质量
记者注意到,不合格的羽绒服,主要是含绒量、绒子含量、充绒量等项目达不到国家标准要求。这三个指标的核心,是羽绒的质量和含量。
大加利(太仓)质量技术检测中心高级工程师 姜文良:据我们了解,羽绒里面鹅绒的价格比较高,纯的鹅绒每吨大约68万元,90%的鹅绒每吨大约63万元,纯的鸭绒每吨大约40万元,90%的鸭绒每吨大约30万元,羽丝每吨大约六到七万元,羽毛每吨大约六到七千元。
也就是说,鹅绒的绒朵比鸭绒更大,鹅绒的蓬松度和保暖性能更好。一般来说,纯鹅绒价格最高,它大约是纯鸭绒的1.7倍,是羽丝的10倍,是羽毛的100倍。
记者观察发现,在这次监督抽查中,一些生产企业“以次充好”标注原材料,是不合格产品存在的主要质量问题。

苏州市纤维检验院检验部工程师 张丹丹:这条围巾它吊牌上显示的是96%的羊毛,但是我们实测下来,它是100%聚酯纤维,就是100%涤纶,就是里面一根羊毛都没有。
苏州市纤检院和深圳市英柏检测技术有限公司对40批次围巾进行检测后发现,不合格产品在标注纤维含量时,大多数把一些价格便宜的化纤成分,虚假标注成羊毛或羊绒等价格更高的原料。
这条围巾标注的成分是羊毛和羊绒各占50%,记者看到检测结果却显示,它根本没有羊绒成分,所谓的“羊绒”其实是“聚酯纤维”,也就是涤纶。
这款不合格的围巾,是从电商平台七匹狼旗舰店购买的,记者看到,这家网店的产品详情介绍中,商家却向消费者出示了一份检测合格报告。

苏州市纤维检验院检验部高级工程师 魏红:它提供了质检的报告,其中对耐水色牢度、耐汗渍色牢度、耐干摩擦色牢度进行了质检,但是并没有对产品标准以及国家强制性标准的甲醛、PH值、偶氮、纤维含量等项目进行质检,可以看出这份质检报告并不齐全,但这一次我们的监督抽查检测过程中发现,它的纤维含量项目不合格。
经过检测,不合格的围巾,包括标称为七匹狼牌、 标称为雷郭堡牌、 标称为百瑞欧牌等10批次。

苏州市纤检院和常州纤检所对50批次棉服的检测结果显示,生产企业对衣物的纤维含量,随意胡乱标注,是不合格产品存在的另一个质量问题。据了解,纤维含量是消费者选购衣物的重要参考指标,它关系到消费者的穿着体验和使用性能,而且还和衣物的洗涤要求和方法息息相关。
常州市纤维检验所工程师 陈菲:像这件,它标注的是100%的聚酯纤维,但实际我们检测出来是100%的锦纶。像这件它标注了有粘纤,但是我们实际检测出来是锦纶,粘纤吸湿性比较好,但锦纶是一种相对耐磨性比较好的纤维,常用在袜子等服装中。像这件它面料标注了有氨纶,但是我们实际检测是100%聚酯纤维,氨纶是一种弹性的纤维。
检测人员认为,这个指标不合格,主要是生产企业的质量意识淡薄。
常州市纤维检验所工程师 陈菲:有些企业面料进厂之前没有进行检验,还有成品出厂前也没有进行合格检验,有些企业的质量意识比较薄弱,没有按照标准来进行标注。
经过检测,不合格的棉服,包括标称为VERO MODA维沙曼牌、标称为恒源祥牌、标称为姿忆秀牌等10批次。

记者梳理不合格产品名单时发现,多家知名品牌的产品,在这次监督抽查中被判为不合格:包括标称为雪中飞实业有限公司生产的“雪中飞”牌成人羽绒服,经过检测,含绒量、绒子含量和蓬松度等三项指标不合格;标称为桐乡卓玛服饰有限公司生产的“七匹狼”牌围巾,纤维成分不合格;标称为绫致时装(天津)有限公司生产的“VERO MODA 维沙曼”牌棉服,纤维含量不合格。
打造质量不能靠“想象力”
打造质量不是凭想象力,而是靠实打实。刚才看到冬季用品上标称的和实际相差太大了,有的虚标含100%鹅毛、98%羊毛,里面连一根鹅毛、羊毛都没有,有的还标着私人定制、高端、至尊字样,但实打实的品质在哪里呢?这次监督抽查还根据消费者投诉热点,专门对直播平台进行了抽查。
采访中记者还发现,这次监督抽查买样的电商平台超过10家,包括京东、天猫、苏宁易购、唯品会、小米有品、淘宝直播、天猫直播、 抖音、快手、小红书等。据了解,这是江苏省市场监管局首次根据消费者投诉热点,在直播平台开展抽查。
江苏省市场监管局监督处副处长 郭亮:直播平台一共抽查了141个批次,发现了20批次的不合格,不合格发现率为14.2%。从直播平台抽查的总体情况来看,第一个我们发现直播平台它的抽查合格率是低于整个电商的抽查合格率;第二个我们发现直播平台的一些直播主,他们的质量意识比较薄弱,对自己的产品质量并没有,或者销售的产品并没有做质量把关,所以导致一些三无、假冒伪劣这个现象还是存在的。
调查中记者看到,这次监督抽查,多家检测机构在直播平台买样,实际收货时,有一些是三无产品。
南京质检院江苏省户外中心助理工程师 李庆:我们在彬彬家纺直播间购买样品时,主播宣称这床被子含有95%的白鹅绒,我们下单购买了两床羽绒被,实际我们收到的样品是没有生产企业信息,没有吊牌,属于三无产品。
据了解,这次羽绒被的抽查,南京市质检院计划买样25批次,仅在一家电商直播平台买到的样品,就有4批次是三无产品。
南京质检院江苏省户外中心高级工程师 阎燕:直播平台抽检的样品有4批次是三无产品,都没有标注厂名厂址,还有的没有标注绒子含量,还有的所使用的标准不是羽绒被的标准,这些样品不符合我们监督抽查的要求,只能退货。
记者在调查中了解到,这次监督抽查中,检测机构收到的三无产品,都来自电商直播平台,类别包括羽绒被、羽绒服、围巾、冲锋衣等,对此,市场监管部门表示,将加大对这类销售渠道和平台的监管力度。
江苏省市场监管局监督处副处长 郭亮:下一步我们江苏省市场监管局将会继续在电商,特别是在直播领域强化监督抽查,坚决打击一些销售假冒伪劣、三无产品的这种销售行为和店家,为我们广大的消费者提供一个公平公正的消费环境。
直播带货,消费者可以更直接听到、看到对商品的介绍,似乎会多一份信任,没想到这次监督抽查发现,三无产品都来自电商直播平台。有业内人士表示,特别是羽绒制品的内在品质消费者无法鉴别,羽绒制品容易成为掺杂使假的重灾区。其实无论是直播带货类的线上消费,还是实体店类的线下消费,变的仅仅是买卖方式的不同,不能变的是诚信、品质的底线不能被跨越、消费者的权益不能随意被侵犯。
来源:央视新闻客户端
最新更新时间:03/28 16:24



评论